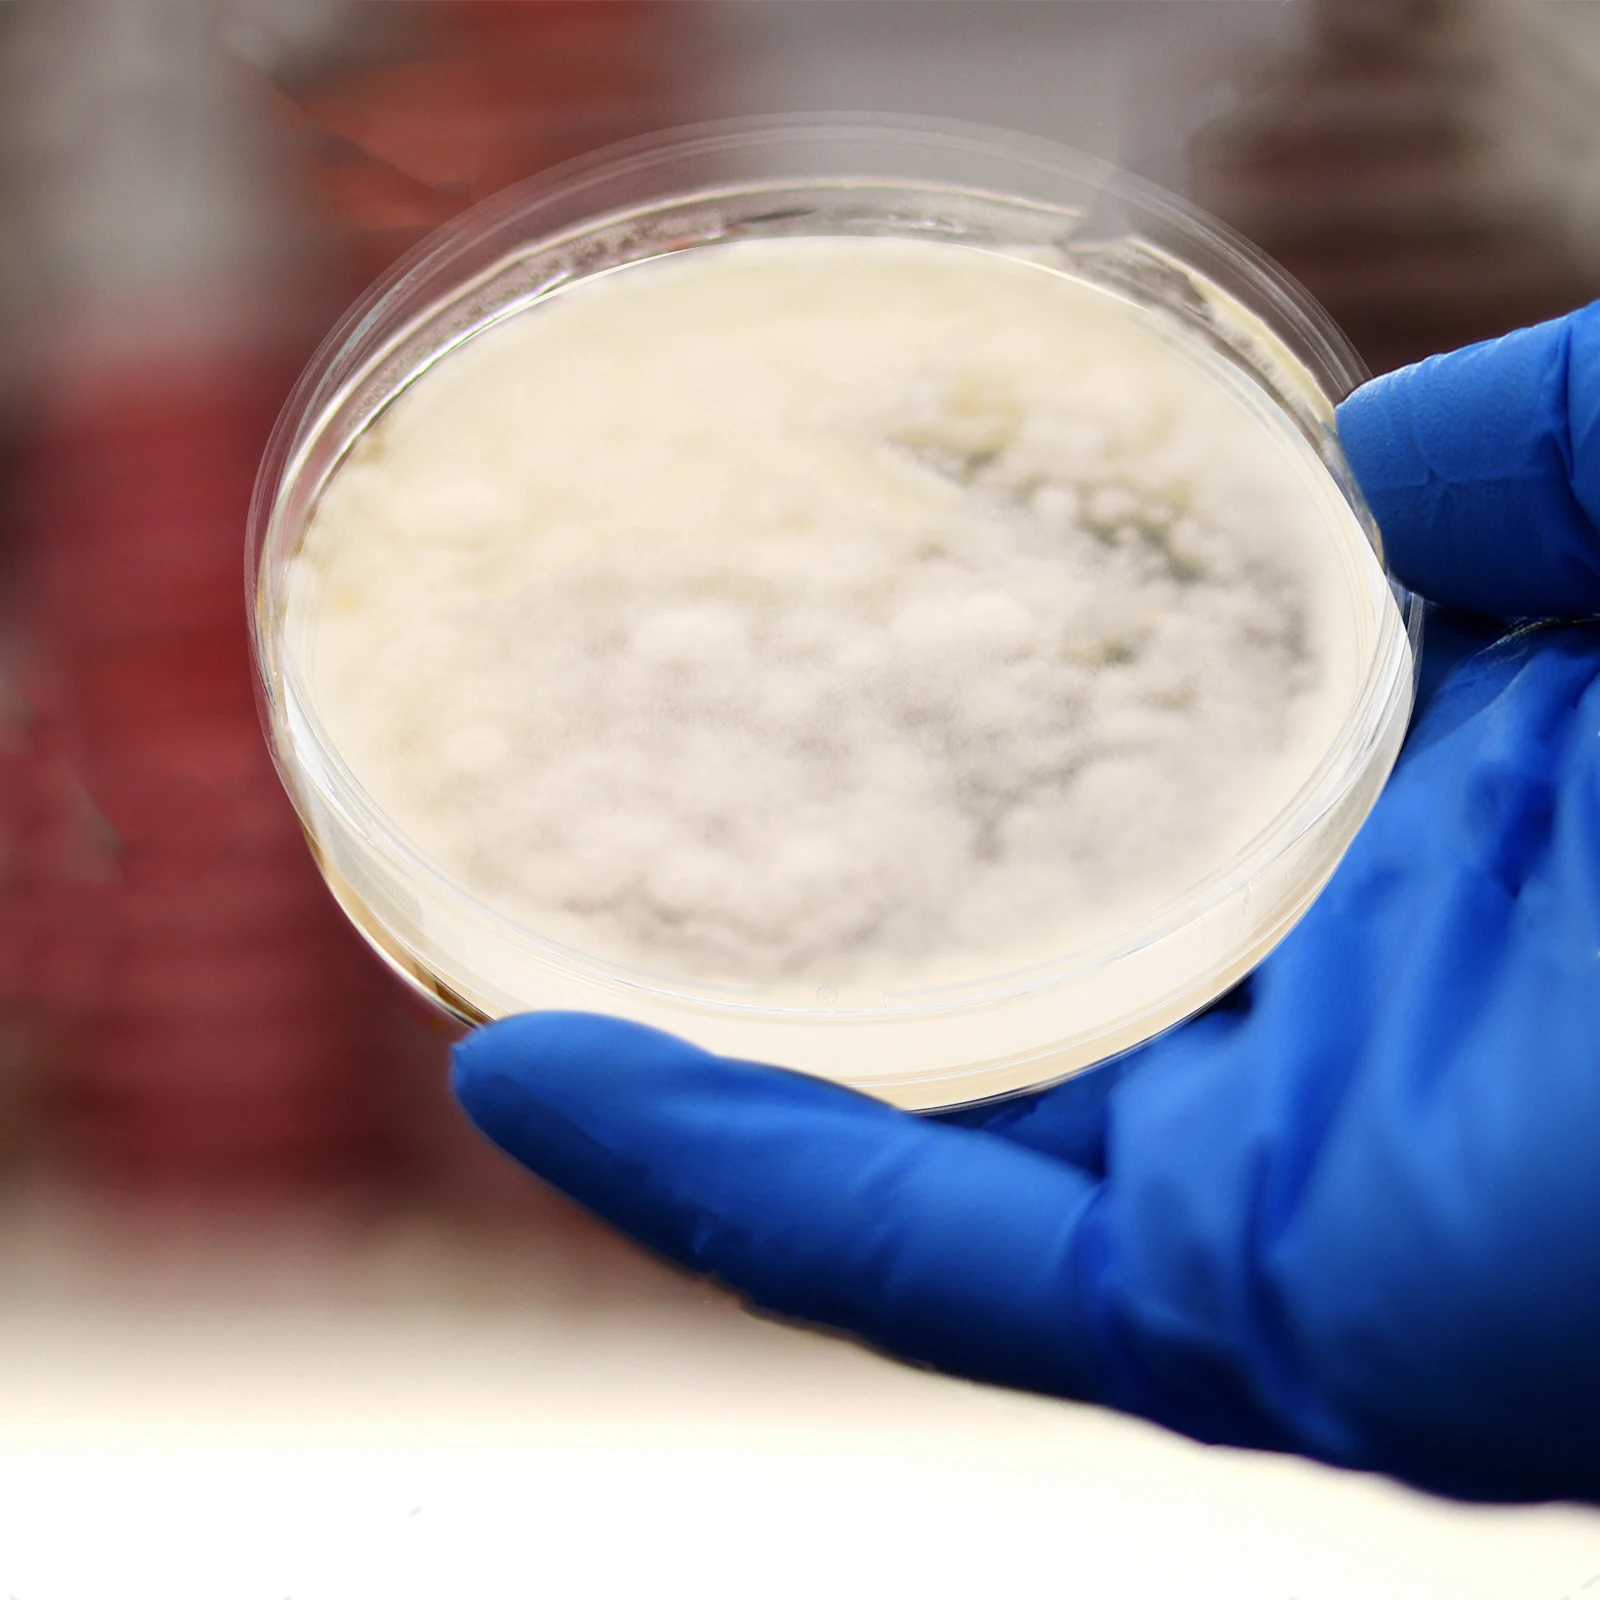

Вафли Gastone Lago Poker Limone с лимонной начинкой 150 г

Gastone Lago
sku: 100036471162
ACCORDING TO OUR RECORDS THIS PRODUCT IS NOT AVAILABLE NOW
169.00 руб.
Shipping from: Russia
Price history chart & currency exchange rate
Customers also viewed

2,458.48 руб.
Winter Ski Gloves Men Women Waterproof Ultralight Gloves Motorcycle Riding Snow Keep Warm Windproof Touchable Screen Gloves
aliexpress.com
2,760.05 руб.
Stair Tread Template Tool 9Inch-54Inch Adjustable Length Stair Measuring Tool Jig for Stair Treads Suitable for Stairs
aliexpress.com
2,783.82 руб.
Комплект контроллера дисплея, часть скутера, костюм акселератора, контроллер приборной панели, акселератор, электрический скутер, новинка
aliexpress.com
4,635.87 руб.
Автомобильный пульт дистанционного управления из углеродного волокна для AUDI A6 TT A3 Q3 A1 A4 Q7 S3, автомобильный Стайлинг
aliexpress.com
4,888.27 руб.
PASS QUEST for Rotor Gravel Bike 3mm Offset AERO Round Narrow Wide Chainring Direct Mount Crank AXS 12 Speed Chain 42-54T ALDHU
aliexpress.com
16,998.73 руб.
Vongrasig 7 Pieces Patio Furniture Sets, Outdoor All-Weather Wicker Patio Conversation Sets, L-Shaped Rattan Sectional Patio
aliexpress.com
23,208.02 руб.
DANMI 1/2" Air Impact Wrench Twin Hammer Tools High Torque Pneumatic Auto Repair Tool
aliexpress.com
11,491.00 руб.
Brennenstuhl светодиодный настенный светильник для наружного освещения "AL 3050" Высота: 16,5 см, серый
cdek.shopping
1,065.34 руб.
Hello Kitty Sanrio Backpack, Kuromi Cinnamoroll Cute Daypack, Cartoon Anime Schoolbag Bag, Girl Casual Travel Commute Knapsack
aliexpress.com
1,192.36 руб.
25cm Eighteen Curtain-chan Sexy Anime Girl Figure Curtain-chan illustration by B-Ginga Action Figure Collectible Model Doll Toys
aliexpress.com
1,759.45 руб.
Подарочный набор ручек для мужчин, 6 в 1, многофункциональный инструмент, ручка, рождественские подарки для папы, многофункциональная ручка, прочная и легкая установка
aliexpress.com
1,048.13 руб.
Large Capacity Women's Backpack Retro Waterproof Nylon Travel Backpack Zipper School Bag Students
aliexpress.com
65,088.17 руб.
For Mercedes Benz W204 W218 W214 W212 A-Class/C-Class/E-Class Steering Wheel Carbon Fiber
aliexpress.com
196,510.12 руб.
4wd Aluminium Camper Pickup Truck Camping Ute Trays Canopies Hardtop for Jeep Gladiator Colorado
aliexpress.com
430.23 руб.
Настольный Автомобильный увлажнитель воздуха для ароматерапии, миниатюрная Светодиодная лампа-капля с ароматом для офиса
aliexpress.ru
629.37 руб.
Роскошный чехол для чемодана с цветочным рисунком в гавайском стиле в стиле бохо, защита от круиза, практичные принадлежности для полета, принадлежности для багажа
aliexpress.ru
422.86 руб.
America Travelling Souvenirs California Fridge Magnets United States Refrigerator Stickers Christmas Gifts Photo Wall Stickers
aliexpress.ru
679.36 руб.
Держатель наждачной бумаги шлифовальный Полировочный инструмент, деревообрабатывающий абразивный инструмент, настенный инструмент для шлифовки гипсокартона, плоской древесины
aliexpress.ru
2,746.94 руб.
Широкие брюки с высокой талией в стиле ретро, повседневные Прямые брюки с плюшевой подкладкой
aliexpress.ru
1,831.57 руб.
Базовые элегантные футболки Winsleter, модель осенне-весенней коллекции 2023 года, новые женские Сексуальные облегающие сетчатые топы с V-образным вырезом и принтом с рюшами T38433JC
aliexpress.ru
269.61 руб.
Pairs Kindergarten Footprints Stickers Small Ankles Floor Stickers Waterproof Adhesive Floor Bathtub Sticker (Mixed Color)
aliexpress.com
132.76 руб.
Женские кружевные комплекты с бюстгальтером, бесшовное нижнее белье, жилет с открытой спиной, сексуальные трусики, Бралетт, нижнее белье, тр...
aliexpress.ru
2,622.38 руб.
Велосипедная Джерси на заказ, летний зимний костюм для триатлона и катания на коньках на заказ, костюм для плавания и бега, мужской велосипе...
aliexpress.ru
4,519.50 руб.
Пылесборник с Hepa-фильтром для Irobot Roomba 800, 900, 860, 864, 870, 880, 885, 890
aliexpress.ru
934.22 руб.
15 штук латунные туманообразующие сопла 1/4 дюйма Противоскользящий замок мистер сопла резьба туманообразующая сопла тройники с 2 штуками за...
aliexpress.ru
2,249.51 руб.
Демисезонная Мужская куртка, мужские куртки, мужская куртка, мужские модные куртки 2021, мужские повседневные куртки в стиле Хай-стрит, карго
aliexpress.ru
1,462.79 руб.
Woman Flat Platform Sandals Women Soft Leather Buckle Casual Shoes sandaleas de mujer Open Toe Gladiator Wedges Women Sandals
aliexpress.ru
2,211.81 руб.
Часы-браслет женские кварцевые из нержавеющей стали под розовое золото с бриллиантами
aliexpress.ru
3,904.88 руб.
Универсальные светодиодные противотуманные фары для мотоциклов 40 Вт 6000K, фары с реле для R1200GS K1600 F800GS F700GS F650GS
aliexpress.ru
20,159.51 руб.
Женский меховой жилет, классический теплый жилет из натурального Лисьего меха, Осень-зима
aliexpress.ru
570.37 руб.
Impact Ball Golf Swing Trainer Aid Practice Posture Movement Training Exercise Adjustment Accessories Automatic Corre W1v2
aliexpress.ru
515.46 руб.
Фонарь светодиодный с пассивным инфракрасным датчиком движения 10/15/21/30/50 см
aliexpress.ru
99.16 руб.
Creative Novelty Children Kid Favor Gift Toy Cartoon Animal Rabbit Sleep LED Table Night Light Rabbit Lamp Color Changing
aliexpress.com
28,499.00 руб.
Кроссовки Vapor Edge 360 Untouchable Mid, цвет White Purple Iridescent, Белый, Кроссовки Vapor Edge 360 Untouchable Mid, цвет White Purple Iridescent
cdek.shopping
1,507.87 руб.
Quilted Coats for Women 2024 Autumn Stand Collar Chic Single-breasted Jacket Ladies Solid with Pockets Cotton Coat
aliexpress.com
22,288.00 руб.
Наплечная сумка Mindesa, морской, Синий, Наплечная сумка Mindesa, морской
cdek.shopping
358.12 руб.
10pcs Agar Plates Disposable Nutrient Agar Medium Vacuum Packaging Long Term Use Determine Biological Equipment Science Fair
aliexpress.ru
1,370.19 руб.
Детский классический костюм с блестками: многослойная тюлевая юбка с небольшой курткой, подходит для дней рождения и фестивалей.
aliexpress.ru